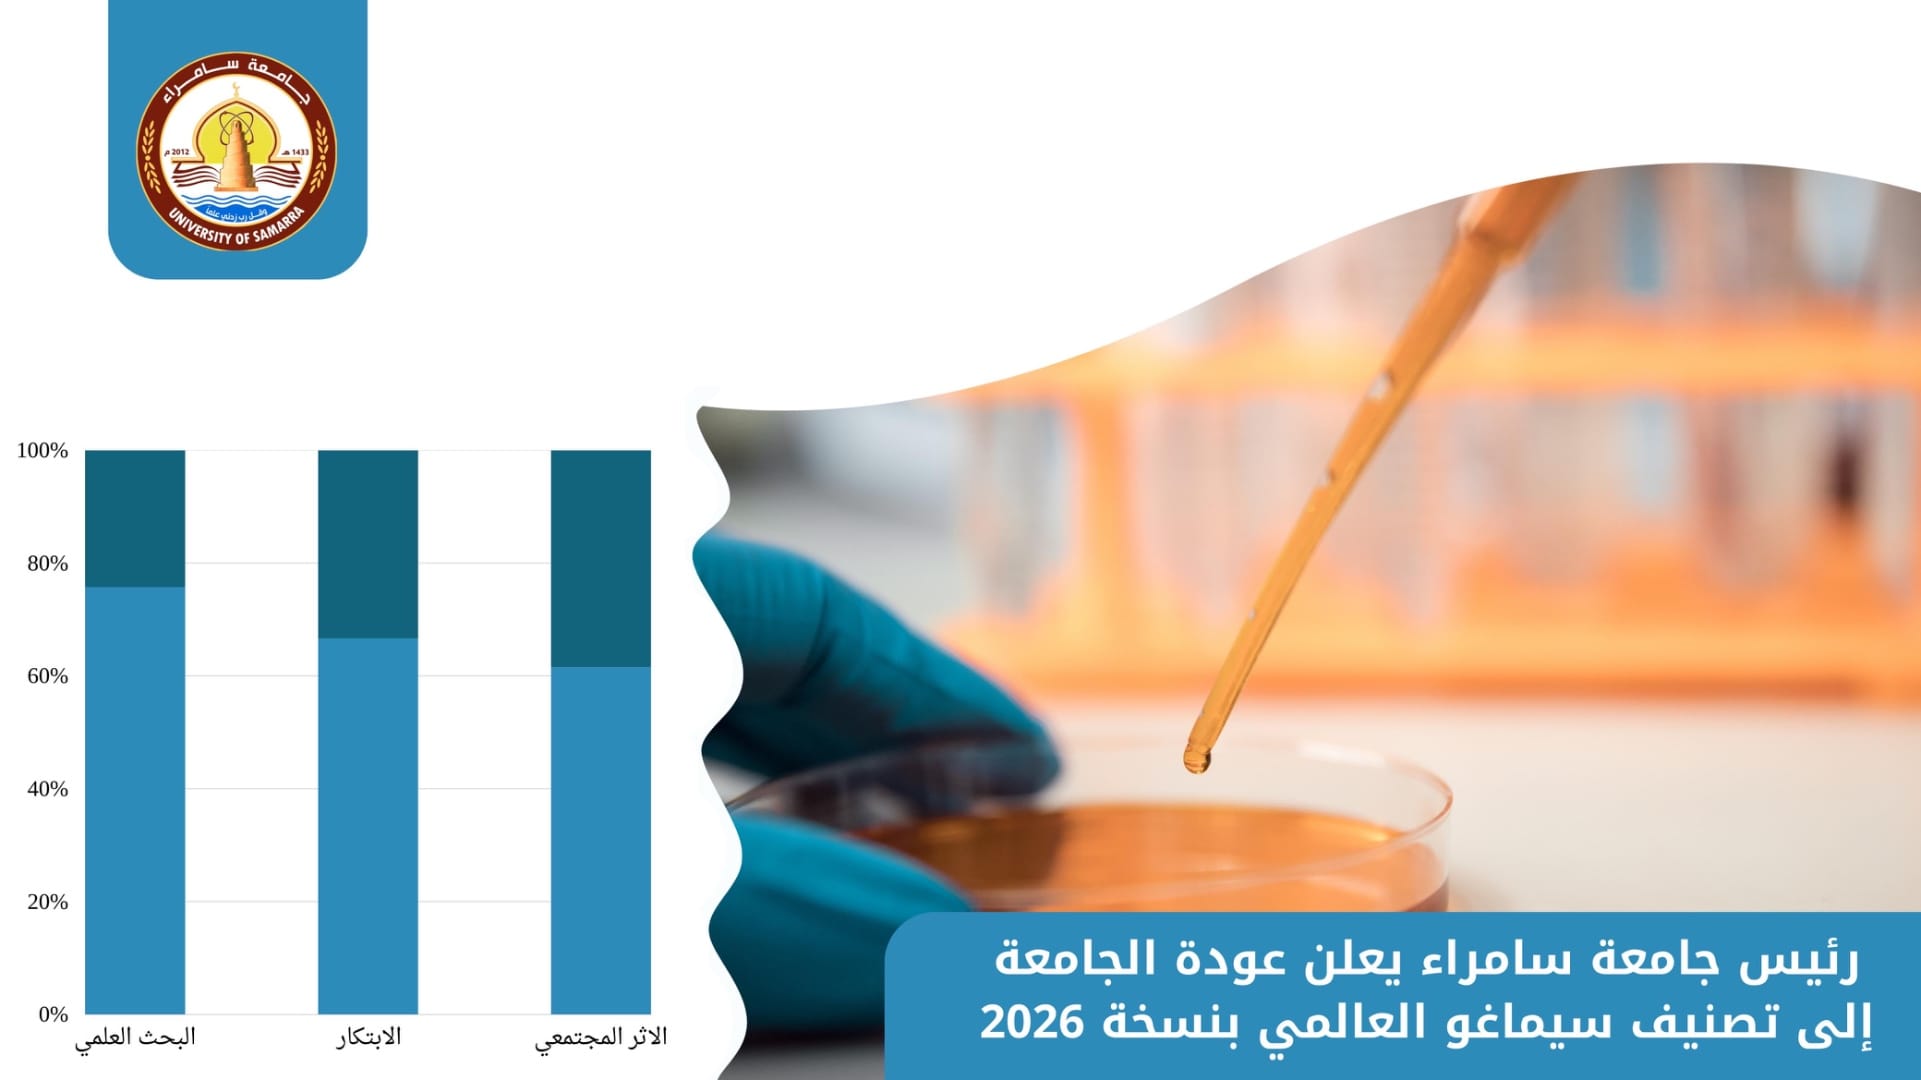

رئيس جامعة سامراء يعلن عودة الجامعة إلى تصنيف سيماغو العالمي بنسخة 2026
أعلن رئيس جامعة سامراء الأستاذ الدكتور (صباح علاوي السامرائي) عودة الجامعة للمنافسة في تصنيف سماغو الاسباني العالمي (SJR) في نسخة 2026، الصادرة في يوم الثلاثاء الموافق 3 آذار الحالي، وبروزها بين الجامعات العراقية والعربية والعالمية.
ويعتمد (سيماغو) على البحوث العلمية المنشورة في مستوعب سكوبس وذات معامل تأثير مرتفع وجودة عالية، كذلك براءات الاختراع والابتكارات من نتاجات أساتيذ الجامعة بالتخصصات المختلفة، إضافة إلى مراجعات السير الذاتية للباحثين من ملاك الجامعة والمرفوعة على الموقع الرسمي والمنصة الرقمية للجامعة، وعدد الاقتباسات والاستشهادات ببحوثهم المنشورة.
من جانبه، قدم -رئيس الجامعة- شكره لأعضاء اللجنة الخاصة بالتصنيف؛ لما بذلوه من جهود استثنائية في العمل الدؤوب لرفع اسم الجامعة بين الجامعات العالمية، إضافة إلى تقديره للباحثين من أكاديميي الجامعة لما قدموه من أبحاث علمية بتخصصاتهم الدقيقة، ومشاركتهم الفاعلة في المجلات المنزوية في المستوعبات العالمية الرصينة.